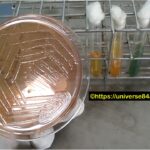
Aeromonas-Introduction, Morphology, Pathogenicity, Lab Diagnosis, Treatment, Prevention, and Keynotes

Tag: and Keynotes
Aural Swab Culture and Sensitivity Test-Introduction, Report, Clinical Significance, Common Pathogens, and Keynotes
Introduction The Aural Swab Culture and Sensitivity Test, also known...
Read MoreStenotrophomonas maltophilia: Introduction, Morphology, Pathogenicity, Lab Diagnosis, Treatment, Prevention, and Keynotes
 Introduction Stenotrophomonas maltophilia is a gram-negative, aerobic, non-fermentative bacterium that...
Introduction Stenotrophomonas maltophilia is a gram-negative, aerobic, non-fermentative bacterium that...
Aeromonas-Introduction, Morphology, Pathogenicity, Lab Diagnosis, Treatment, Prevention, and Keynotes
Introduction Aeromonas is a genus of bacteria that is widely...
Introduction Aeromonas is a genus of bacteria that is widely...
